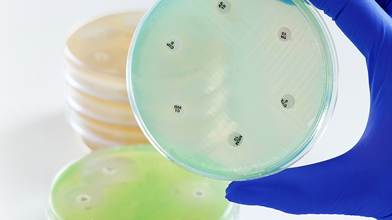
UK_AST_Discs1.png
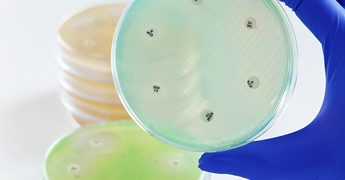
UK_AST_Discs1.png
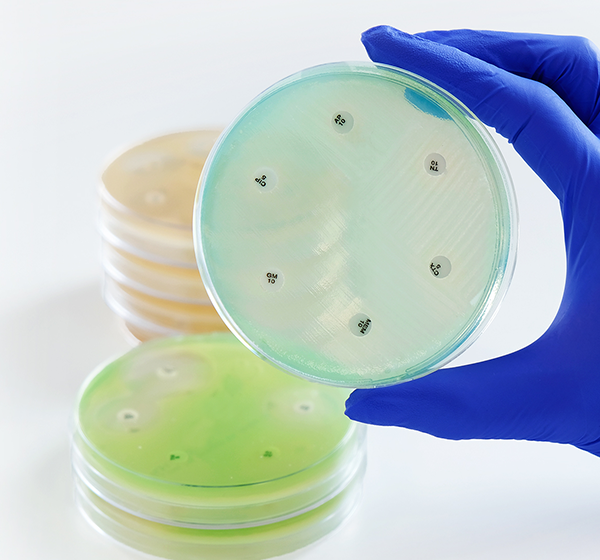
UK_AST_Discs1.png
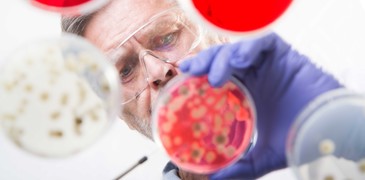
AMR_CATEGORY_PLATES.jpg
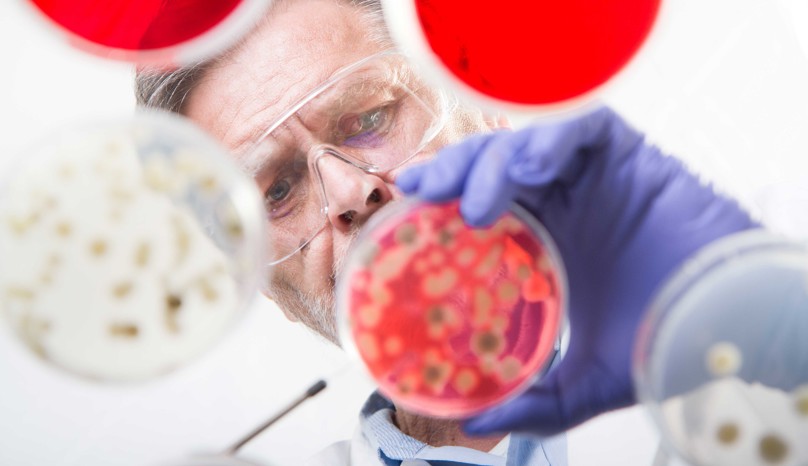
AMR_CATEGORY_PLATES.jpg
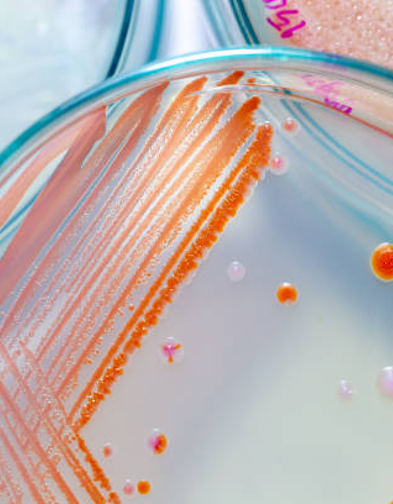
Microbiology
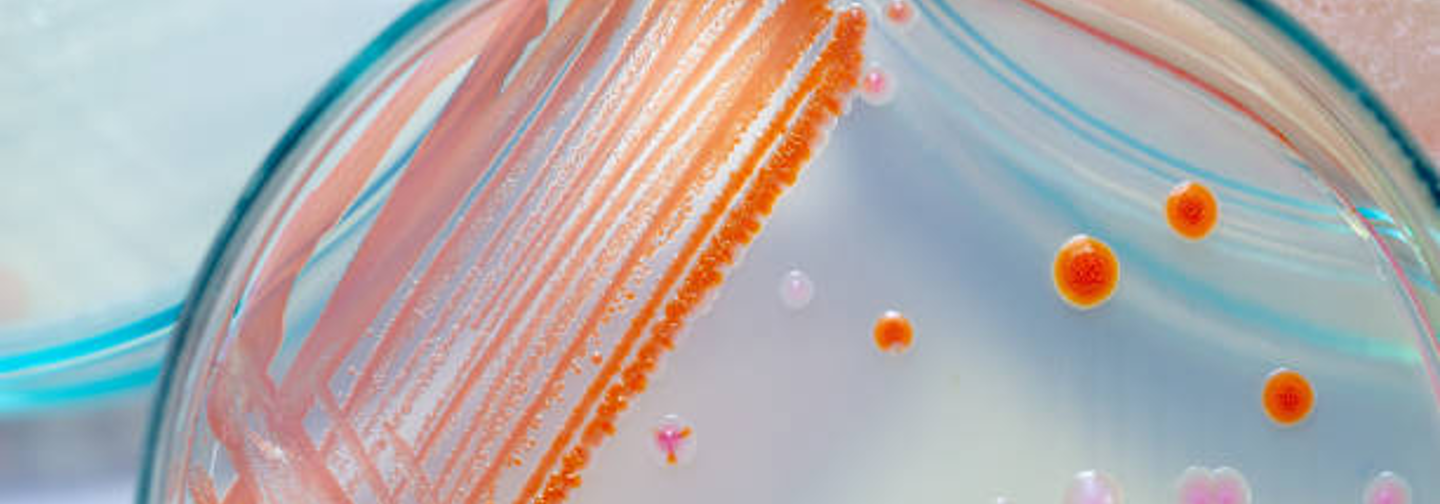
Microbiology

From our earliest developments in antimicrobial susceptibility testing to our continuously expanding product portfolio, we are committed to delivering reliable, innovative, and performance-driven microbiology solutions. Our comprehensive range includes culture media, antimicrobial susceptibility testing products, diagnostic reagents, and laboratory consumables
With a history of experience, quality and innovation, the expansion of the Microbiology portfolio has resulted in the most comprehensive range available world-wide, helping to support laboratories in achieving accurate, consistent, and dependable results.
Discover our microbiology solutions

AST
We are pioneers in AST, with over 65 years of experience developing trusted, high-quality susceptibility testing products.

AMR
Mast offers a wide range of reliable solutions for both screening and confirmatory testing using a variety of technologies including colorimetric tests, combination discs and disc diffusion screening tests.




Culture Media & Supplements
Mast Group offers a wide range of dehydrated culture media for in vitro diagnostic use in clinical microbiology, food microbiology, environmental testing and research microbiology.


Identification & Detection
Mast Group offers a range of products for identification and detection by a variety of methods, incorporating disc testing, biochemical tests, latex agglutination and agglutinating antisera.


Instruments
Mast Group manufactures and supplies a wide range of lab instruments to aid the running of tests




Sample Storage
Proper sample storage is essential in laboratories to maintain the integrity, reliability, and traceability of samples.